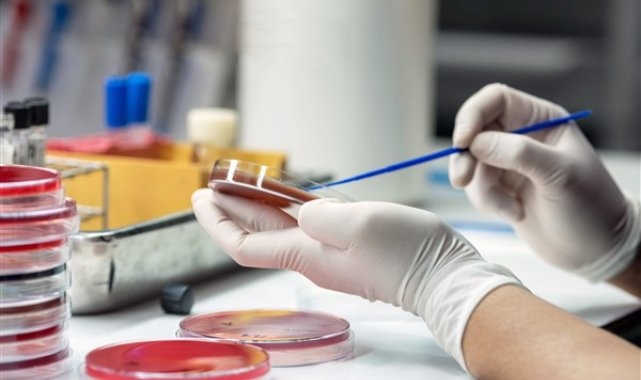

Yeditepe Üniversitesi Kozyatağı Hastanesi Anestezi ve Reanimasyon Anabilim Dalı Yoğun Bakım Uzmanı Prof. Dr. Sibel Temür sepsisi hakkında bilgi verdi.
Sepsisi, bağışıklık sistemimizin enfeksiyona karşı anormal yanıtı ile organ fonksiyon bozukluğuna varan hayatı tehdit eden hastalık durumu olarak tanımlayan Temür, "Bağışıklık sisteminin iyi olmadığı yaş grupları 1 yaş altı, 65 yaş üstü kişiler, dalağı alınmış olanlar, kronik hastalıkları olanlar (akciğer, kalp, böbrek rahatsızlıkları), diyabetikler, AIDS tanısı almış kişilerin sepsis açısından risk grupları arasında yer alıyor.
Sepsisin bakteri, virüs, mantar, parazit gibi tüm olası patojen kaynaklı enfeksiyonlarla tetiklenebilir. Bu nedenle viral pandemi döneminde bağışıklık sistemi iyi olmayanlarda yanıtlar çok üzücüydü. 2 yıl önce, pandemi öncesi veriler yılda 30 milyon sepsis tanısı iken bu rakam pandemi sonrasında 47-50 milyona ulaştı" dedi.
Bununla birlikte son yıllarda tüm dünya için önemli bir sorun haline gelen antibiyotik direncinin de sepsisi olumsuz etkilediğine işaret eden Prof. Dr. Sibel Temür, konuyla ilgili şunları anlattı:
"Antibiyotik direnci, antibiyotiklerin çeşit, miktar ve süre olarak uygunsuz kullanımı ile artıyor. Bakteriyel enfeksiyonlarda elimizde savaşacak silah kalmıyor. Virüsler çok akıllı ve antivirallere direnç çok daha hızlı gelişiyor, yeni varyantlar çıkıyor. Direnç gelişmesi sepsiste tedaviyi olumsuz etkiliyor. Türkiye antibiyotiklere dirençte maalesef Avrupa ülkeleri arasında ilk sırada. Bu da sepsis açısından ayrı bir risk oluşturuyor."
Sepsisin belirtilerinin enfeksiyon odağına göre farklılıklar göstermekle birlikte hastada tüm vücudu ilgilendiren sistemik belirtilerin ortaya çıktığını belirten Prof. Dr. Sibel Temür, hastalığın belirtilerini şöyle sıraladı:
"Hastaların farklı birçok sorunla karıştırdığı belirtiler arasında: Ateş, sersemlik ve geveleyerek konuşma, nörolojik durumda gerileme, aşırı titreme, kas ağrısı, şiddetli nefes darlığı, solunum sayısının dakikada 22 üzerine çıkması, kan basıncının düşmesi, gün boyu idrar yapamama, solgun, benekli, rengi değişmiş cilt ve ölecekmiş gibi hissetme.
Sepsis sonrası sağkalan olgular; taburculuk sonrası ortaya çıkan fiziksel problemler, bilişsel bozukluklar, tekrarlayan enfeksiyonlar veya sepsis ilişkili kronik organ yetmezlikleri ile sağlık kuruluşlarına yeniden başvurmak zorunda kalıyor. Tekrar sağlık kurumuna başvuru oranı çeşitli çalışmalarda değişiklik gösterse de % 50'nin üstünde izleniyor."
"Sepsis dünyadaki en önlenebilir yaşam kaybı nedenidir" diyen Yeditepe Üniversitesi Kozyatağı Hastanesi Anestezi ve Reanimasyon Anabilim Dalı Yoğun Bakım Uzmanı Prof. Dr. Sibel Temür, sözlerine şöyle devam etti:
"Aşılama, temiz sağlık tesislerine, temiz suya erişim gibi sağlık önlemleri ve hepsinden önce farkındalığın artırılmasıyla önlenebilir. Bir enfeksiyon sepsise yol açmışsa hızlı bir şekilde tanınmalı ve enfeksiyonun kaynağı antibiyotiklerle tedavi edilmeli. Enfeksiyonların erken tedavisi ve sepsisin erken tanınması hayat kurtarır. Sepsis tıbbi acil durumudur farkındalık olarak bilinmesi çok önemli. İlk saatlerde yapılan acil müdahale ve kültür alınarak erken antibiyotik tedavisine başlanması sepsisten kayıpları %70 den, % 20 ye düşürebiliyor."
Sepsisi, bağışıklık sistemimizin enfeksiyona karşı anormal yanıtı ile organ fonksiyon bozukluğuna varan hayatı tehdit eden hastalık durumu olarak tanımlayan Temür, "Bağışıklık sisteminin iyi olmadığı yaş grupları 1 yaş altı, 65 yaş üstü kişiler, dalağı alınmış olanlar, kronik hastalıkları olanlar (akciğer, kalp, böbrek rahatsızlıkları), diyabetikler, AIDS tanısı almış kişilerin sepsis açısından risk grupları arasında yer alıyor.
Sepsisin bakteri, virüs, mantar, parazit gibi tüm olası patojen kaynaklı enfeksiyonlarla tetiklenebilir. Bu nedenle viral pandemi döneminde bağışıklık sistemi iyi olmayanlarda yanıtlar çok üzücüydü. 2 yıl önce, pandemi öncesi veriler yılda 30 milyon sepsis tanısı iken bu rakam pandemi sonrasında 47-50 milyona ulaştı" dedi.
Bununla birlikte son yıllarda tüm dünya için önemli bir sorun haline gelen antibiyotik direncinin de sepsisi olumsuz etkilediğine işaret eden Prof. Dr. Sibel Temür, konuyla ilgili şunları anlattı:
"Antibiyotik direnci, antibiyotiklerin çeşit, miktar ve süre olarak uygunsuz kullanımı ile artıyor. Bakteriyel enfeksiyonlarda elimizde savaşacak silah kalmıyor. Virüsler çok akıllı ve antivirallere direnç çok daha hızlı gelişiyor, yeni varyantlar çıkıyor. Direnç gelişmesi sepsiste tedaviyi olumsuz etkiliyor. Türkiye antibiyotiklere dirençte maalesef Avrupa ülkeleri arasında ilk sırada. Bu da sepsis açısından ayrı bir risk oluşturuyor."
Sepsisin belirtilerinin enfeksiyon odağına göre farklılıklar göstermekle birlikte hastada tüm vücudu ilgilendiren sistemik belirtilerin ortaya çıktığını belirten Prof. Dr. Sibel Temür, hastalığın belirtilerini şöyle sıraladı:
"Hastaların farklı birçok sorunla karıştırdığı belirtiler arasında: Ateş, sersemlik ve geveleyerek konuşma, nörolojik durumda gerileme, aşırı titreme, kas ağrısı, şiddetli nefes darlığı, solunum sayısının dakikada 22 üzerine çıkması, kan basıncının düşmesi, gün boyu idrar yapamama, solgun, benekli, rengi değişmiş cilt ve ölecekmiş gibi hissetme.
Sepsis sonrası sağkalan olgular; taburculuk sonrası ortaya çıkan fiziksel problemler, bilişsel bozukluklar, tekrarlayan enfeksiyonlar veya sepsis ilişkili kronik organ yetmezlikleri ile sağlık kuruluşlarına yeniden başvurmak zorunda kalıyor. Tekrar sağlık kurumuna başvuru oranı çeşitli çalışmalarda değişiklik gösterse de % 50'nin üstünde izleniyor."
"Sepsis dünyadaki en önlenebilir yaşam kaybı nedenidir" diyen Yeditepe Üniversitesi Kozyatağı Hastanesi Anestezi ve Reanimasyon Anabilim Dalı Yoğun Bakım Uzmanı Prof. Dr. Sibel Temür, sözlerine şöyle devam etti:
"Aşılama, temiz sağlık tesislerine, temiz suya erişim gibi sağlık önlemleri ve hepsinden önce farkındalığın artırılmasıyla önlenebilir. Bir enfeksiyon sepsise yol açmışsa hızlı bir şekilde tanınmalı ve enfeksiyonun kaynağı antibiyotiklerle tedavi edilmeli. Enfeksiyonların erken tedavisi ve sepsisin erken tanınması hayat kurtarır. Sepsis tıbbi acil durumudur farkındalık olarak bilinmesi çok önemli. İlk saatlerde yapılan acil müdahale ve kültür alınarak erken antibiyotik tedavisine başlanması sepsisten kayıpları %70 den, % 20 ye düşürebiliyor."